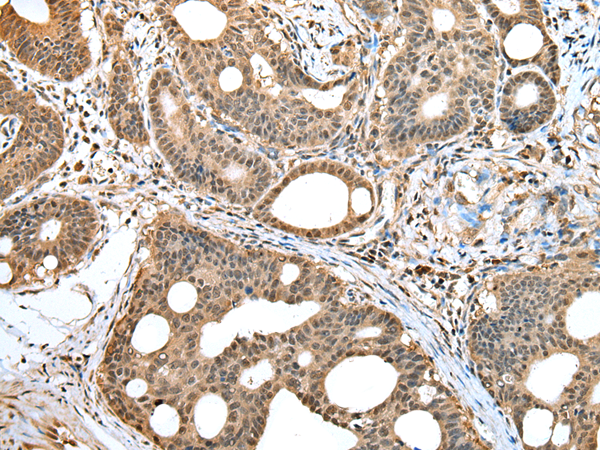

相關類別: 一抗
抗 原: HIF1AN
反應種屬: Human, Mouse
標 記 物: Unconjugate
技術規格
|
Background: |
Hydroxylates HIF-1 alpha at 'Asp-803' in the C-terminal transactivation domain (CAD). Functions as an oxygen sensor and, under normoxic conditions, the hydroxylation prevents interaction of HIF-1 with transcriptional coactivators including Cbp/p300-interacting transactivator. Involved in transcriptional repression through interaction with HIF1A, VHL and histone deacetylases. Hydroxylates specific Asn residues within ankyrin repeat domains (ARD) of NFKB1, NFKBIA, NOTCH1, ASB4, PPP1R12A and several other ARD-containing proteins. Also hydroxylates Asp and His residues within ARDs of ANK1 and TNKS2, respectively. |
|
Applications: |
ELISA, WB, IHC |
|
Name of antibody: |
HIF1AN |
|
Immunogen: |
Full length fusion protein |
|
Full name: |
hypoxia inducible factor 1, alpha subunit inhibitor |
|
Synonyms: |
FIH1 |
|
SwissProt: |
Q9NWT6 |
|
ELISA Recommended dilution: |
5000-10000 |
|
IHC positive control: |
Human gastric cancer and human tonsil |
|
IHC Recommend dilution: |
25-100 |
|
WB Predicted band size: |
40 kDa |
|
WB Positive control: |
Human fetal muscle tissue |
|
WB Recommended dilution: |
200-1000 |

購物車
購物車 幫助
幫助
 021-54845833/15800441009
021-54845833/15800441009
